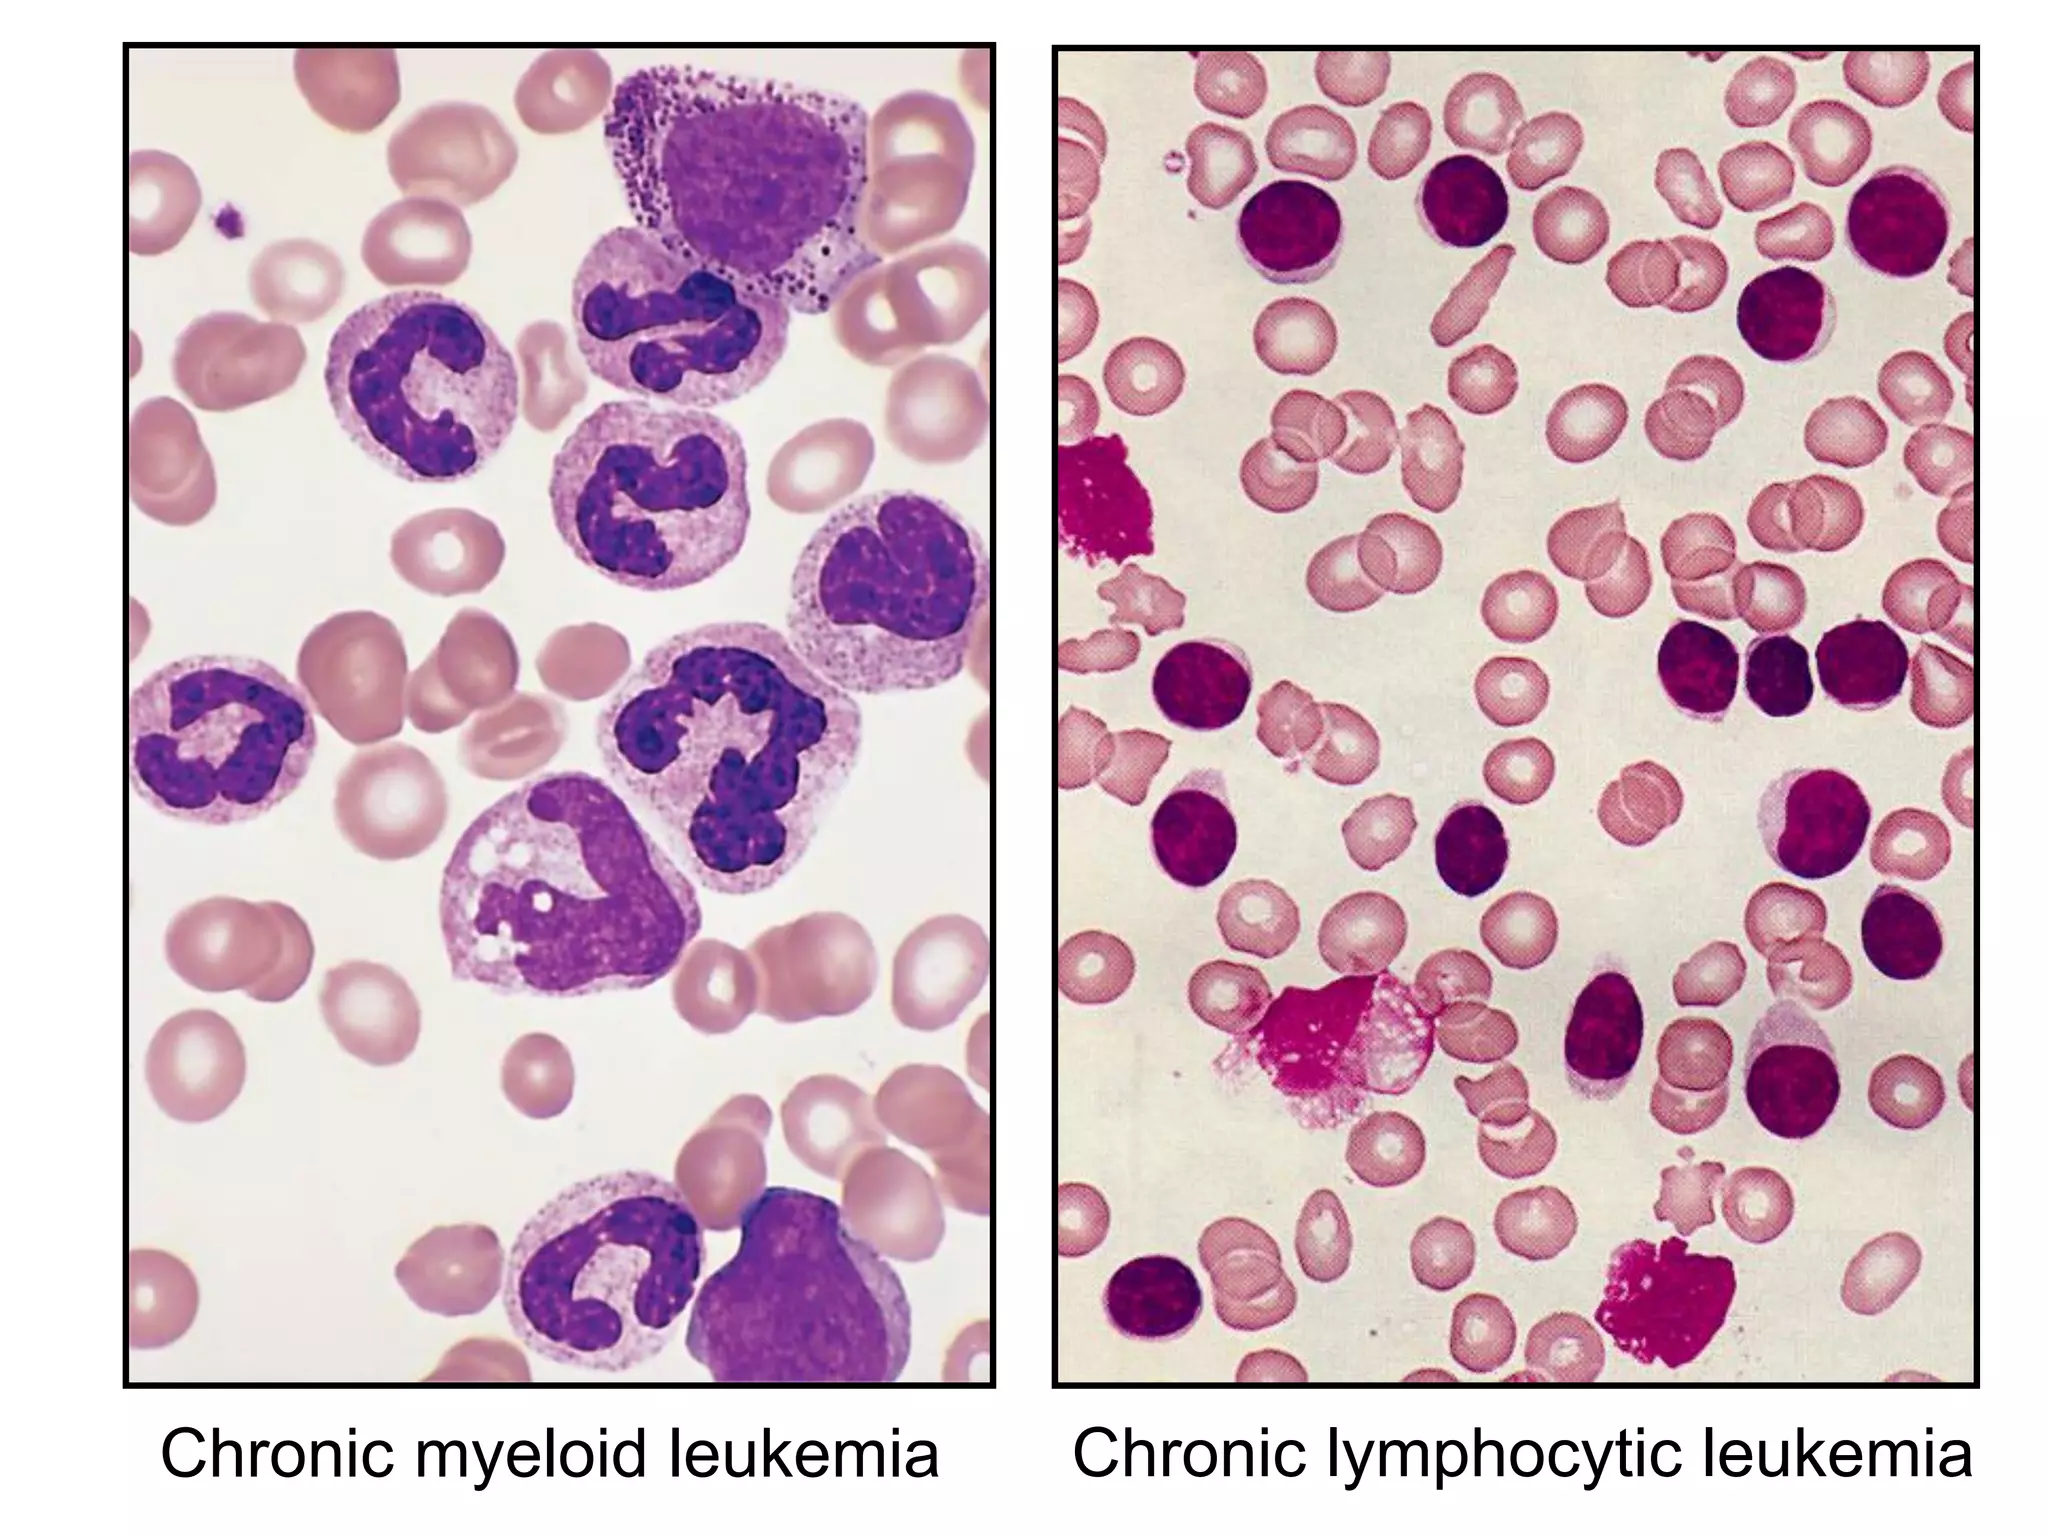
Chronic myeloid leukemia Chronic lymphocytic leukemia
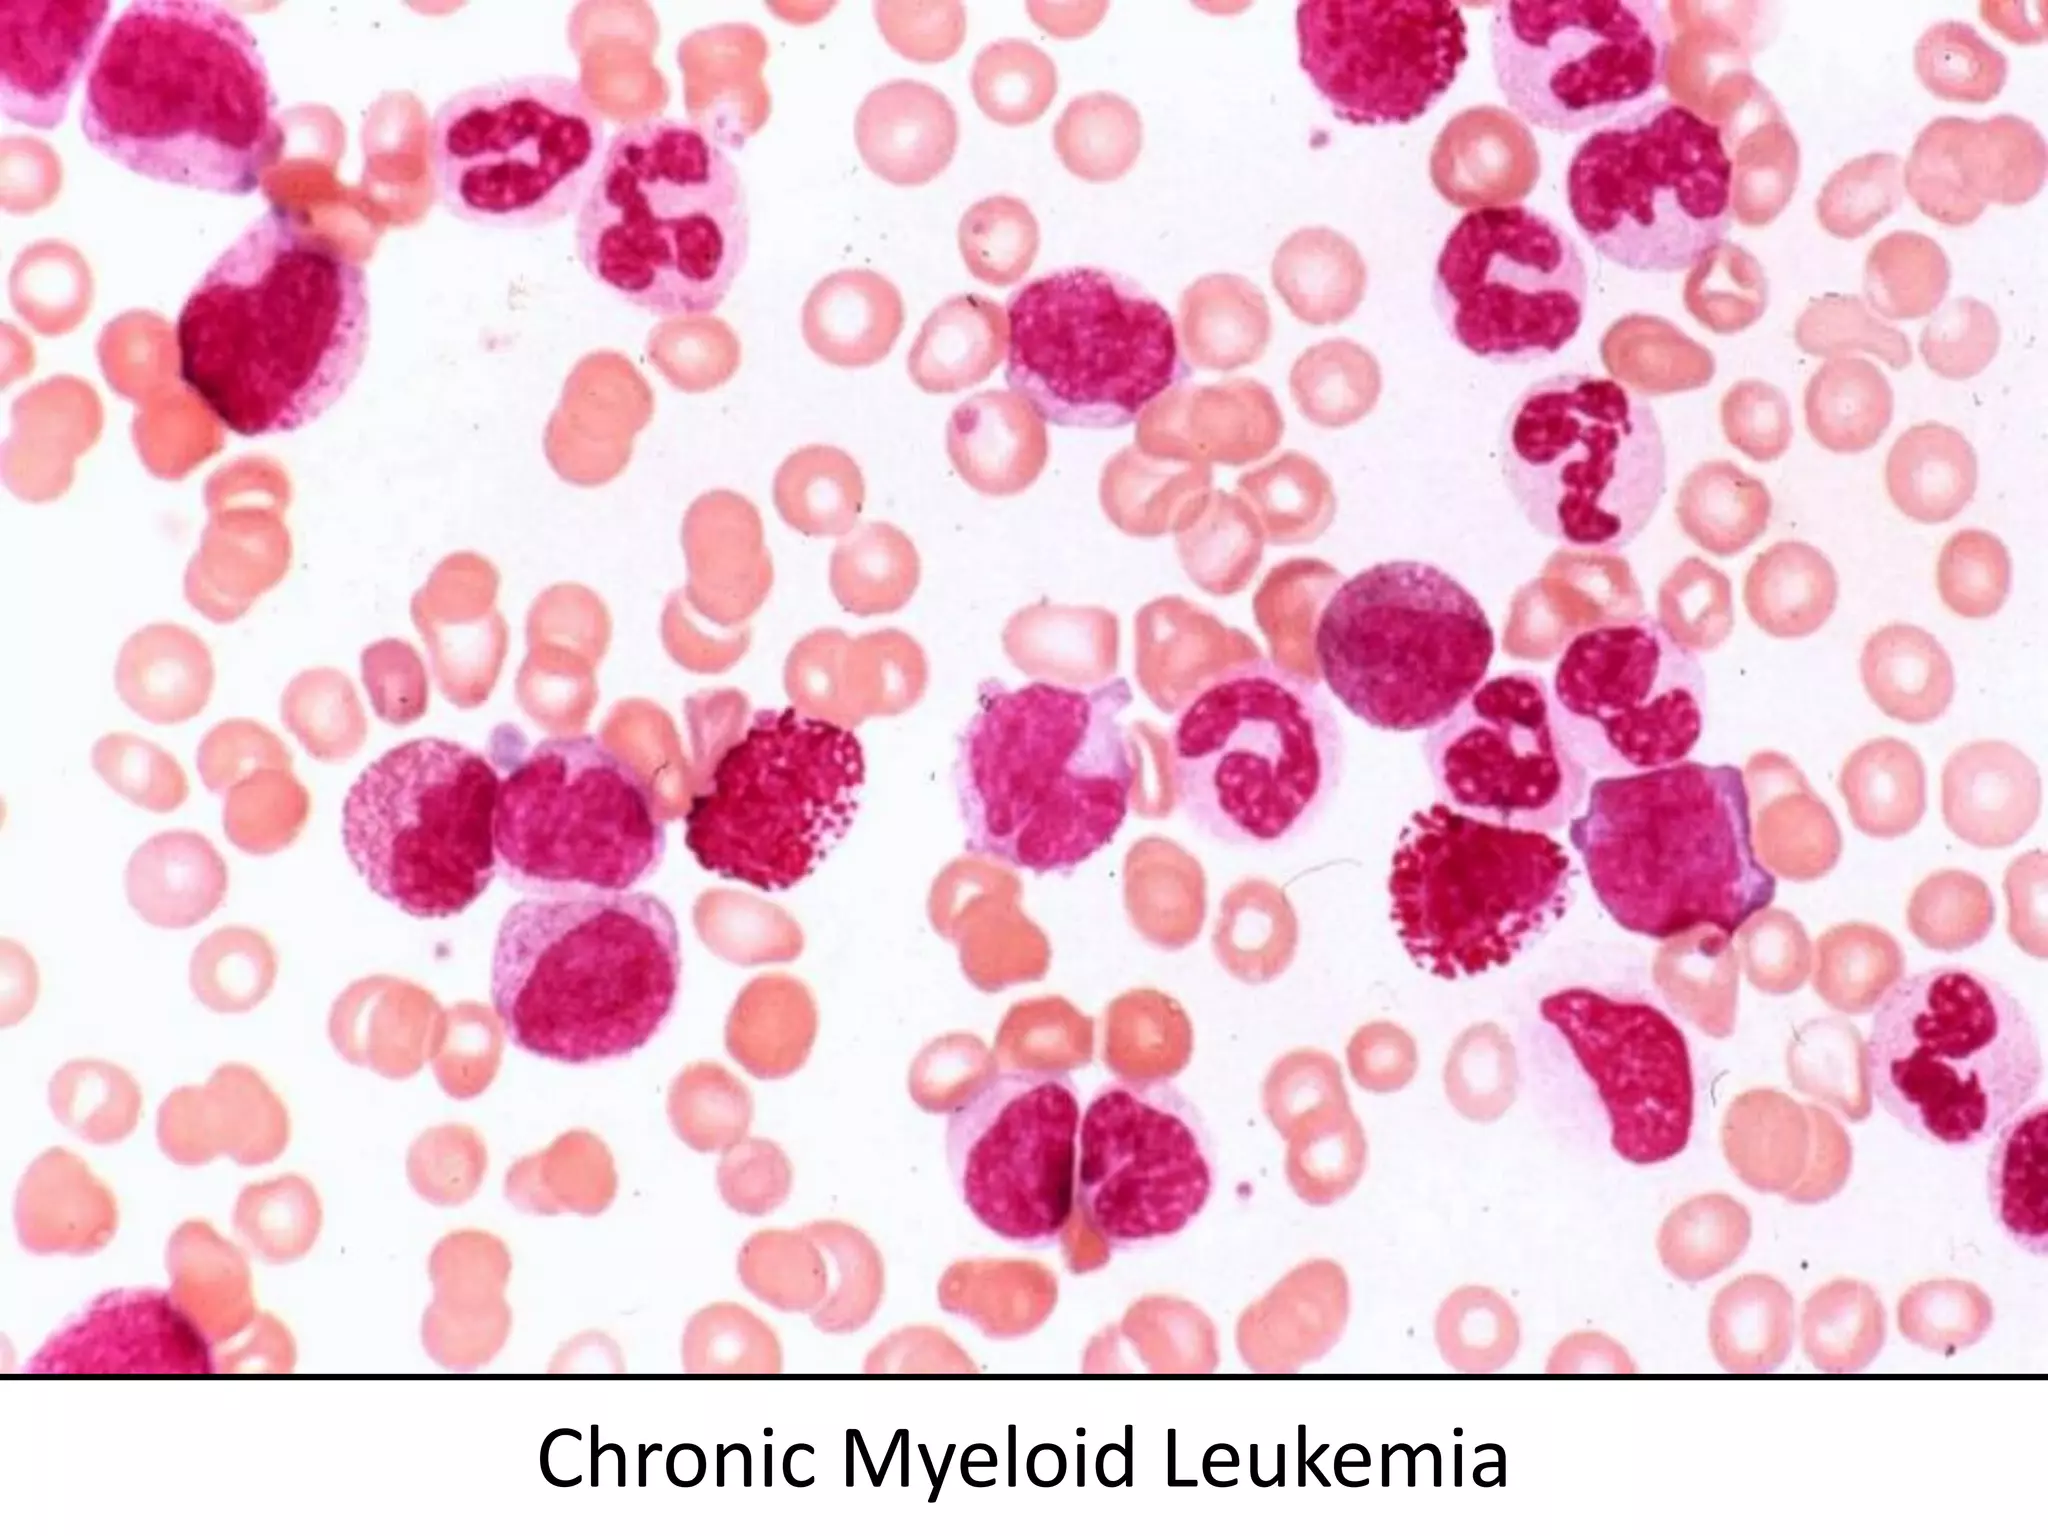
Chronic Myeloid Leukemia
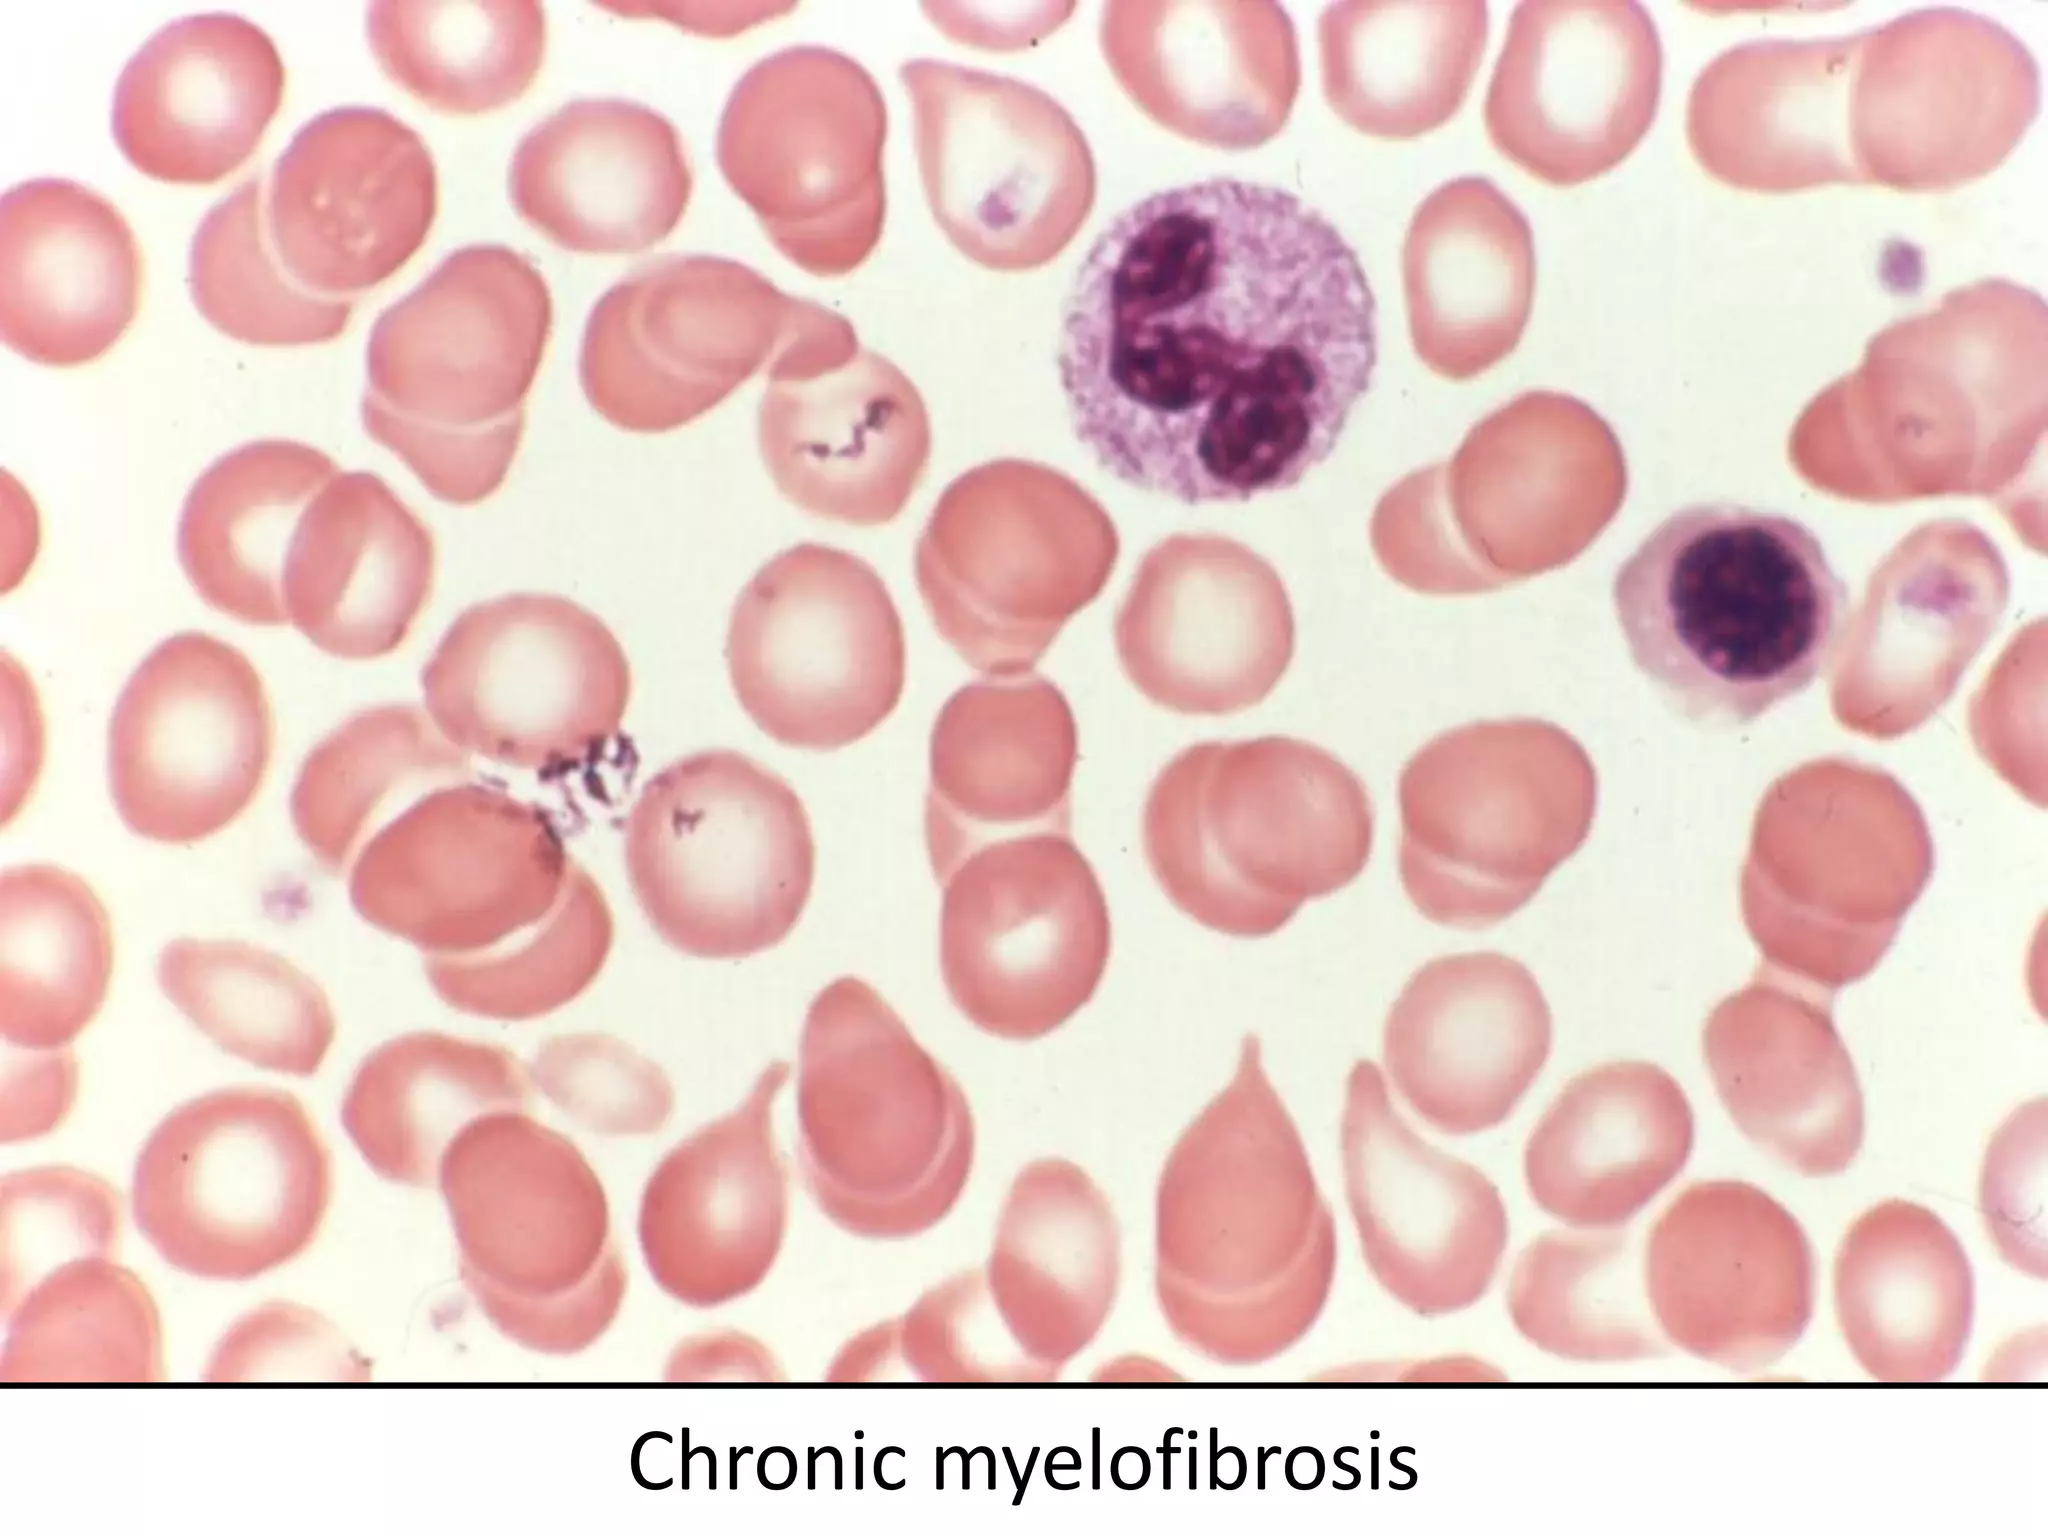
Chronic myelofibrosis
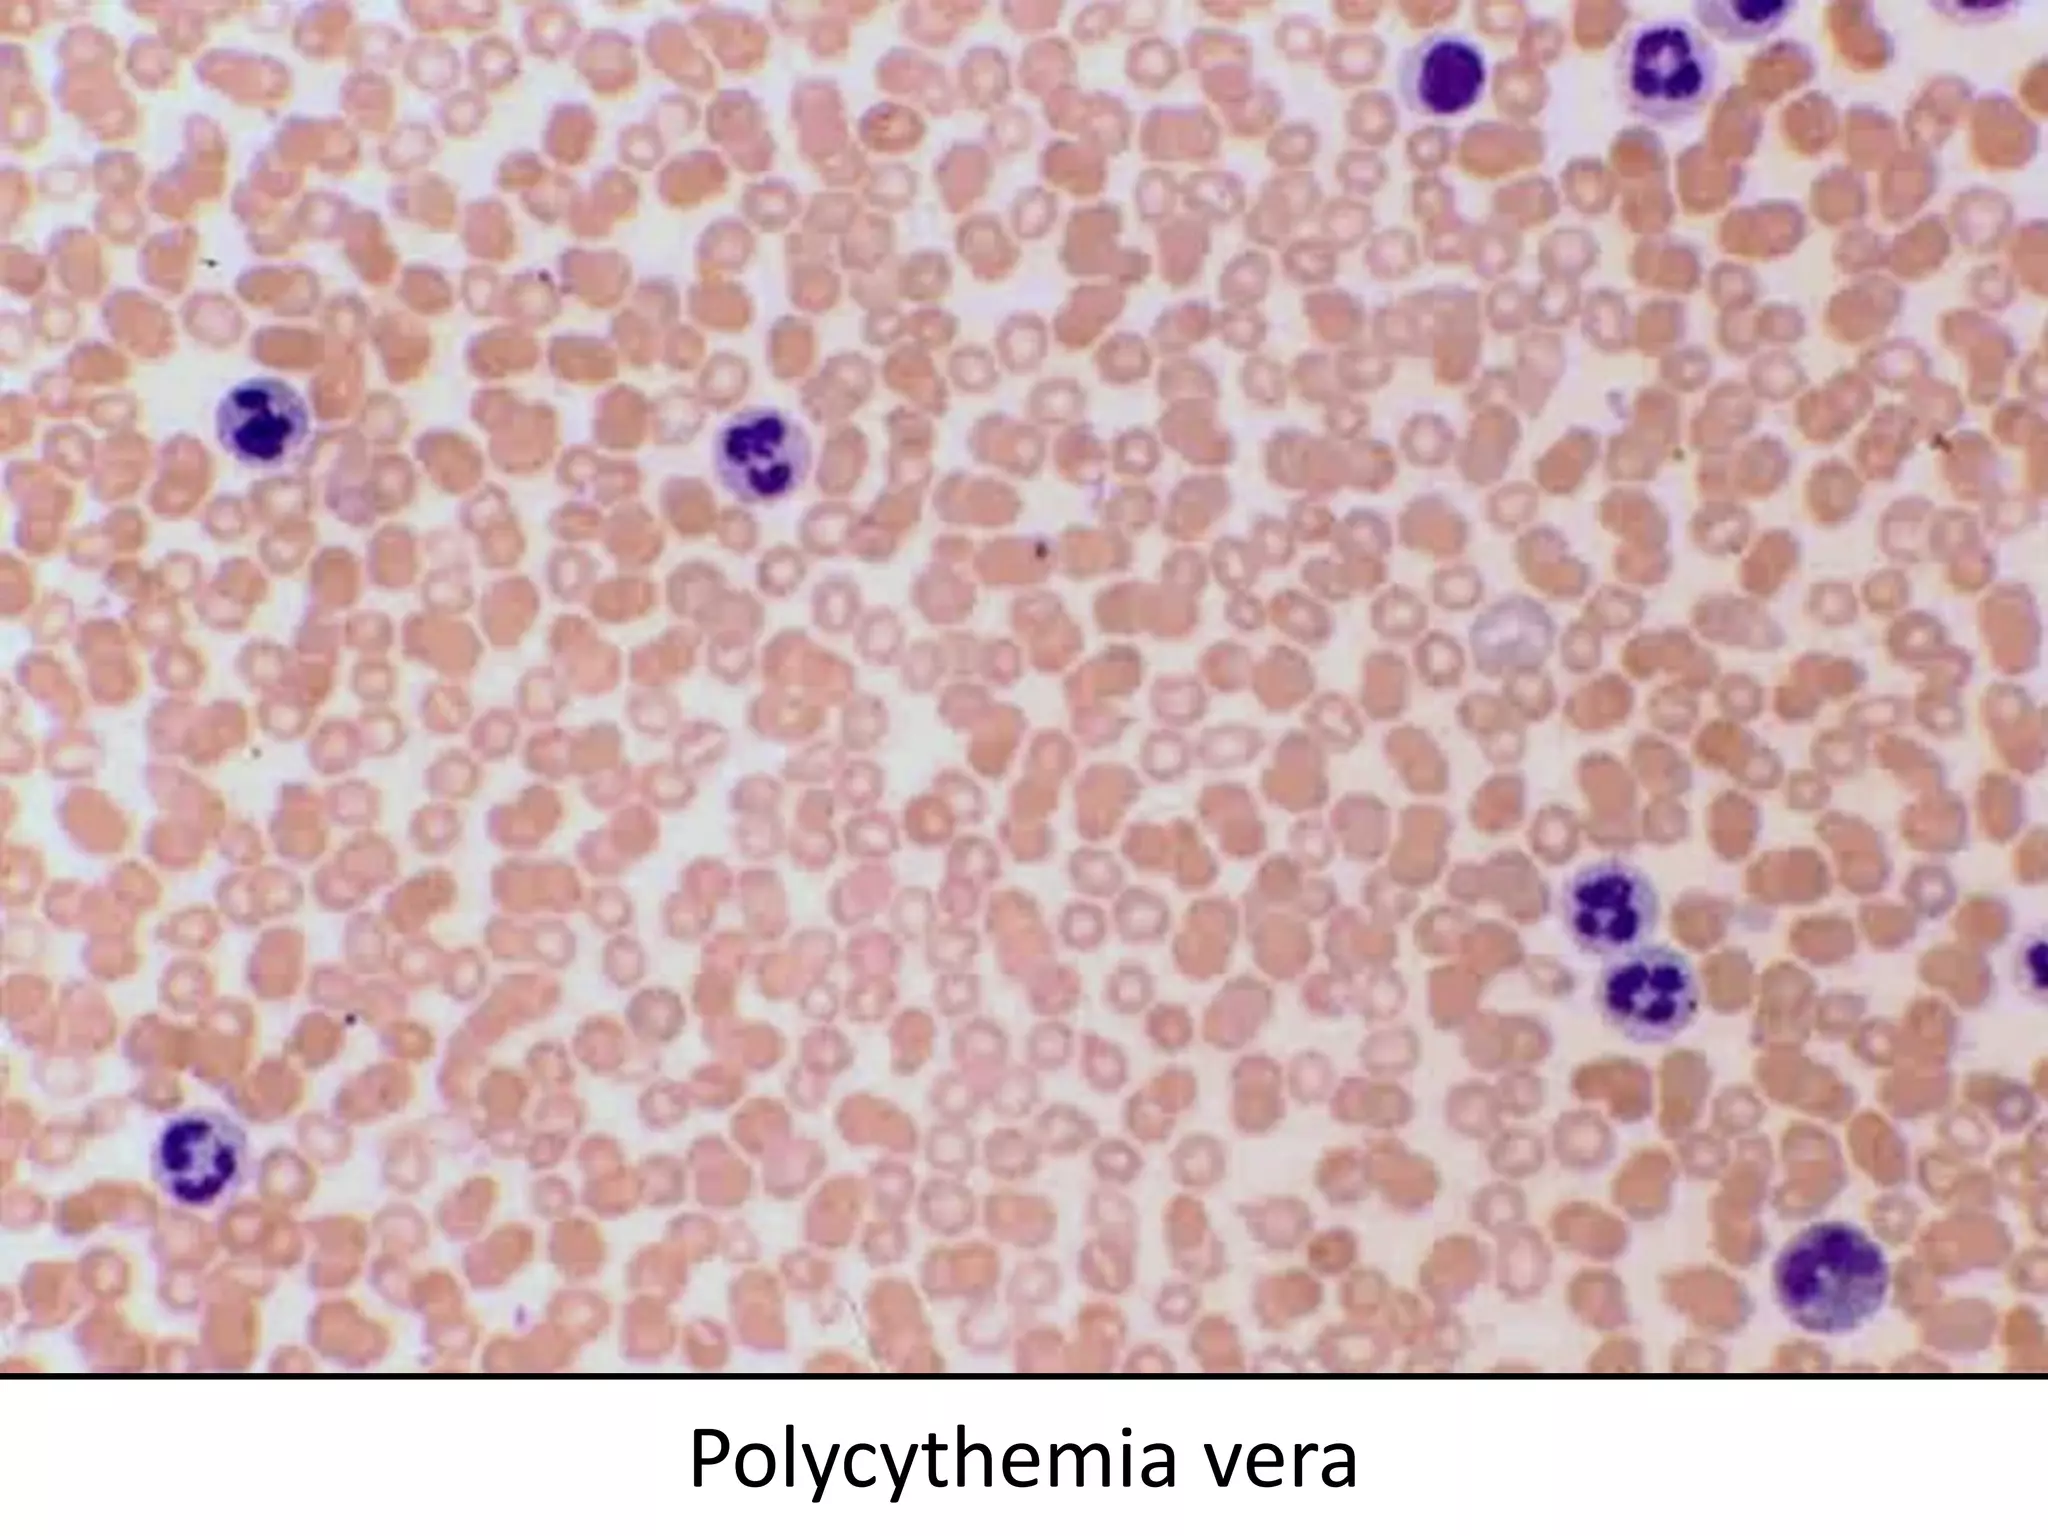
Polycythemia vera
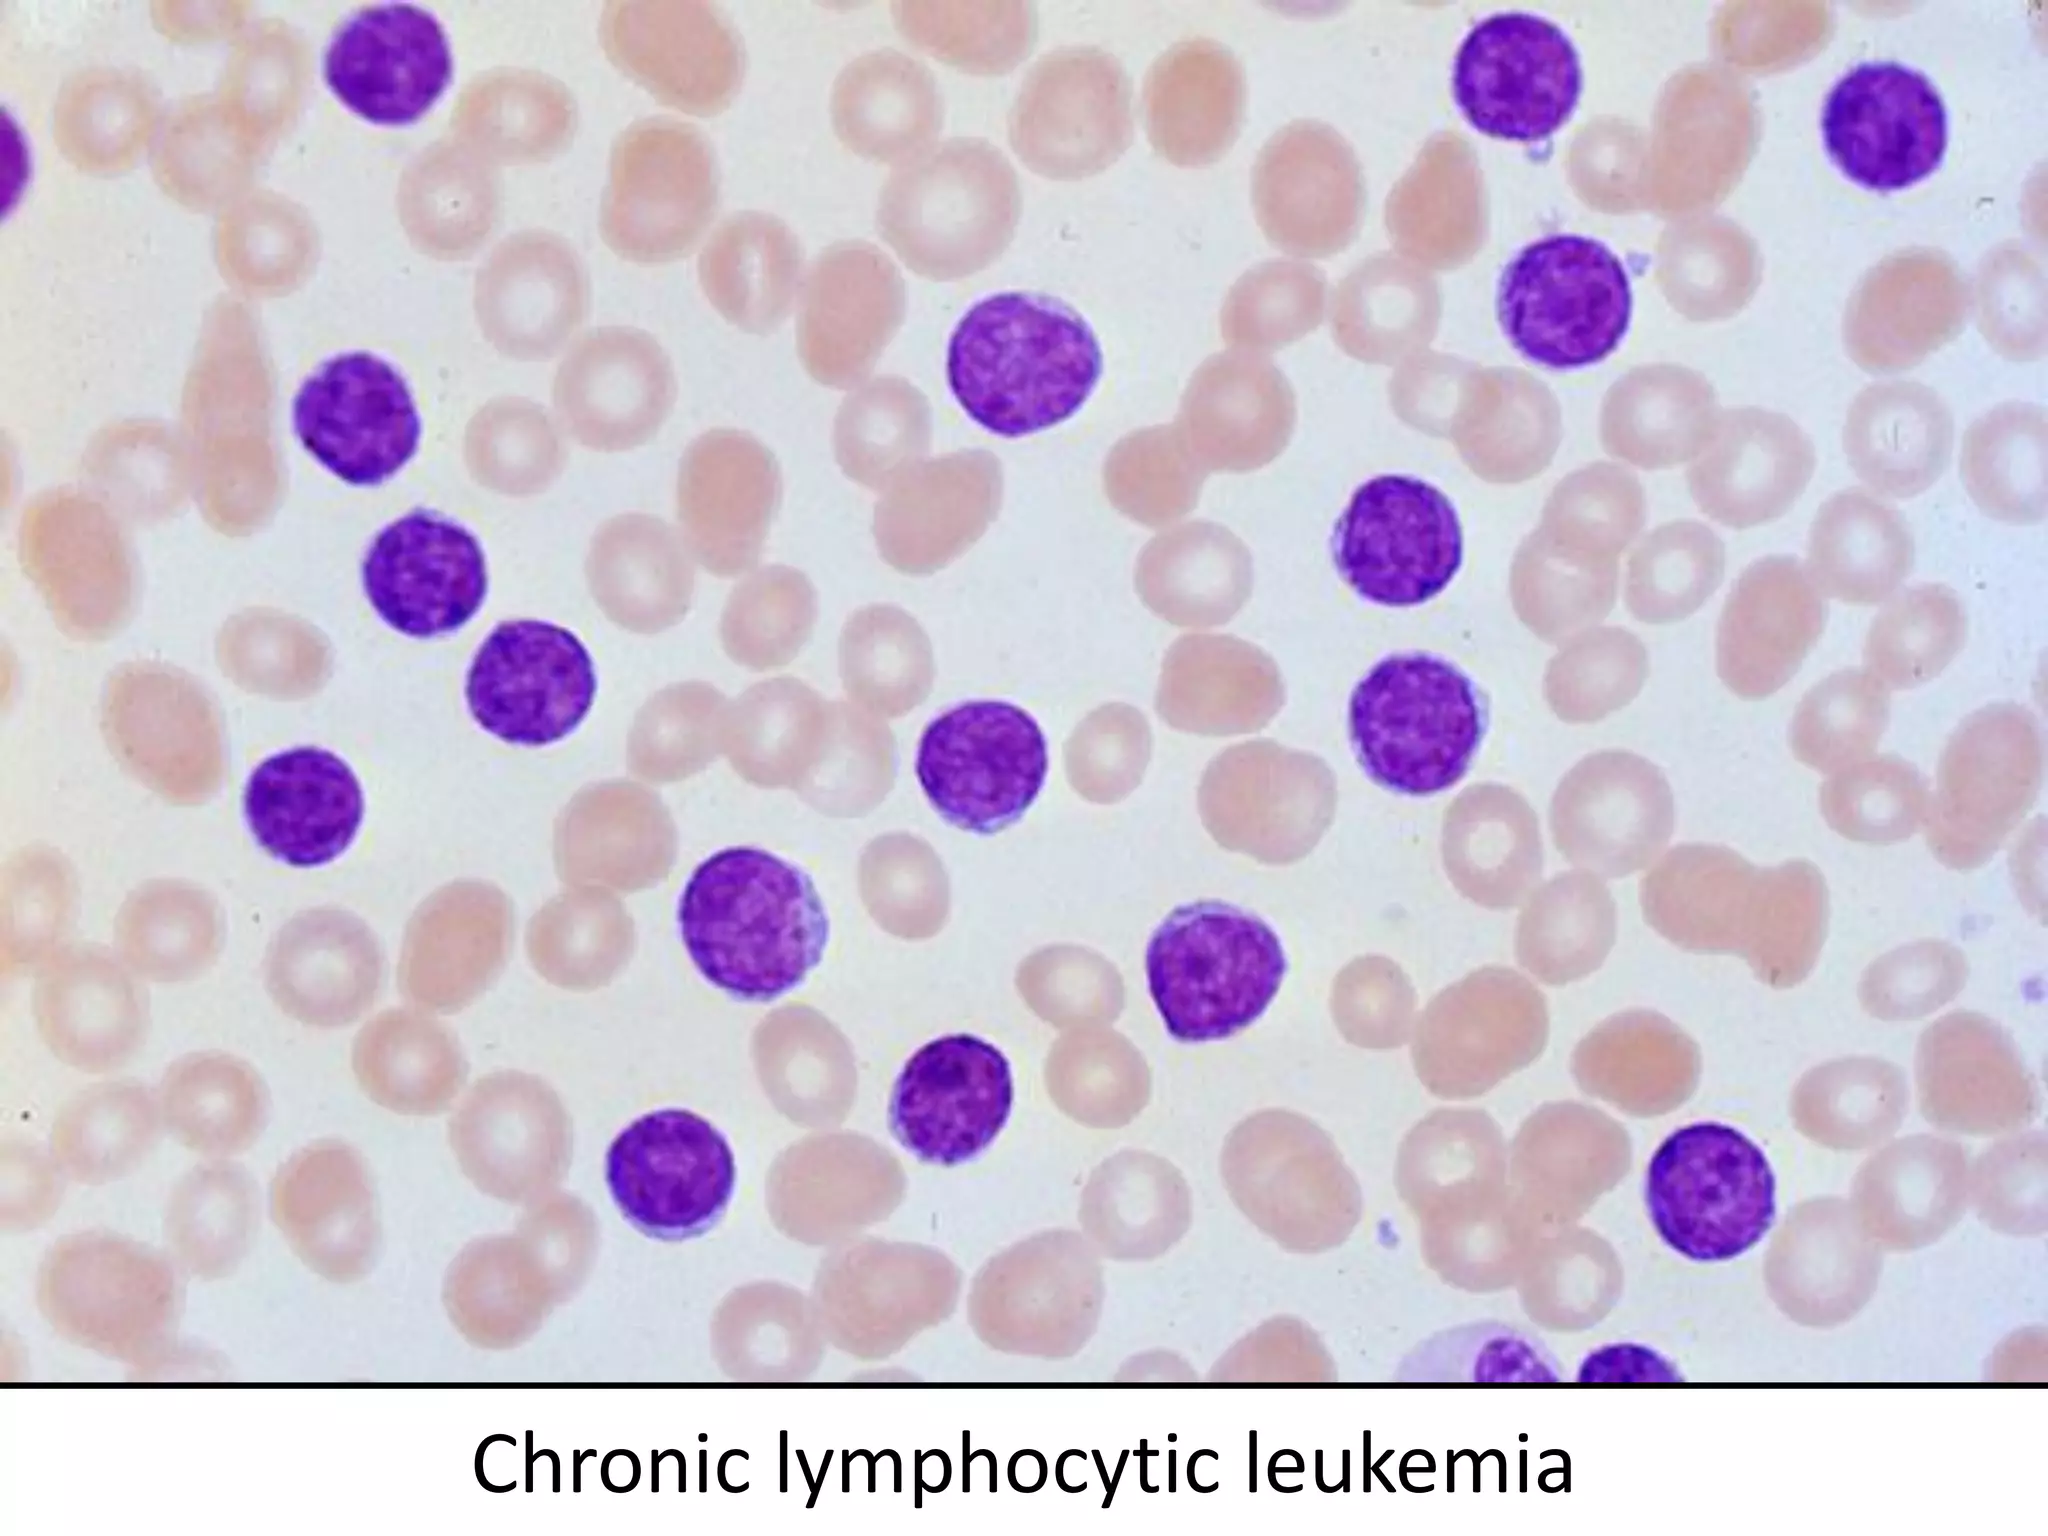
Chronic lymphocytic leukemia

This document discusses several types of hematologic malignancies including chronic leukemias, chronic myeloproliferative disorders, chronic lymphoproliferative disorders, and lymphomas. It provides details on chronic myeloid leukemia, chronic lymphocytic leukemia, polycythemia vera, essential thrombocythemia, chronic myelofibrosis, and their characteristic features, phases or stages of disease progression, treatment approaches, and typical prognosis. The document is an educational reference on several chronic blood cancers and disorders.